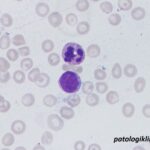
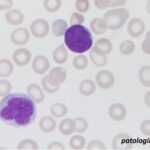
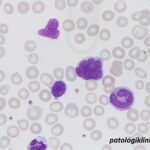
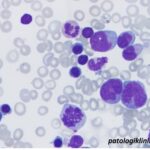

Juvenile Myelomonocytic Leukemia
- Juvenile myelomonocytic leukemia (JMML) merupakan kelainan mieloproliferatif ditandai produksi sel mielomonositik yang berlebihan
- Insiden 1,2/1.000.000 penduduk di US
- Sekitar 3% dari seluruh leukemia pada anak
- Pasien sering kali datang dengan anemia, trombositopenia, infiltrasi organ (hepatomegali, splenomegali, limfadenopati, lesi kulit) dan 50% pasien terdapat peningkatan HbF
- JMML dapat mengalami krisis blas, biasanya dengan morfologi AML M4 atau M5
Kriteria Diagnosis JMML (WHO 2016) berdasarkan klinis dan laboratoris selain studi genetik adalah sebagai berikut:
- Kategori I
- jumlah monosit pada darah tepi >1000/uL
- prosentase blast pada darah tepi dan sumsum tulang <20%
- splenomegali
- BCR-ABL negatif
- Kategori II (pemeriksaan genetik)
- Kategori III
- leukosit >10.000/uL
- peningkatan HbF
- prekursor mieloid atau eritroid di darah tepi
Semoga bermanfaat